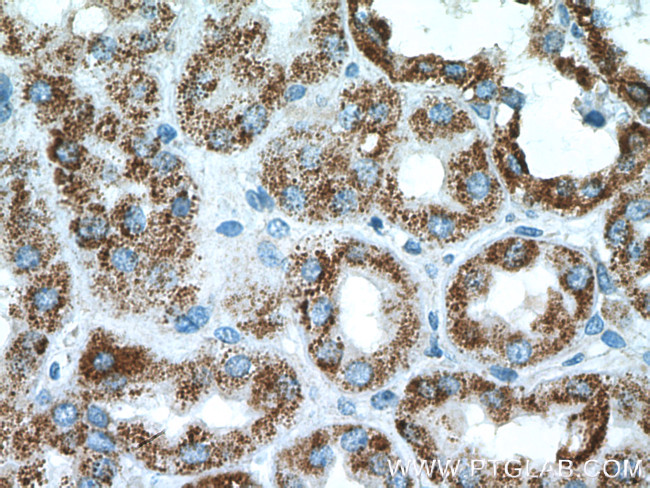
PCCB Antibody in Immunohistochemistry (Paraffin) (IHC (P))
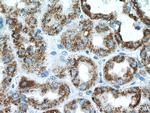
PCCB Antibody in Immunohistochemistry (Paraffin) (IHC (P))

Search
Proteintech
PCCB Polyclonal Antibody
{{$productOrderCtrl.translations['antibody.pdp.commerceCard.promotion.promotions']}}
{{$productOrderCtrl.translations['antibody.pdp.commerceCard.promotion.viewpromo']}}
{{$productOrderCtrl.translations['antibody.pdp.commerceCard.promotion.promocode']}}: {{promo.promoCode}} {{promo.promoTitle}} {{promo.promoDescription}}. {{$productOrderCtrl.translations['antibody.pdp.commerceCard.promotion.learnmore']}}
产品信息
11139-1-AP
种属反应
宿主/亚型
分类
类型
抗原
偶联物
形式
浓度
规格
纯化类型
保存液
内含物
保存条件
运输条件
产品详细信息
Immunogen sequence: TQEELGGAK THTTMSGVAH RAFENDVDAL CNLRDFFNYL PLSSQDPAPV RECHDPSDRL VPELDTIVPL ESTKAYNMVD IIHSVVDERE FFEIMPNYAK NIIVGFARMN GRTVGIVGNQ PKVASGCLDI NSSVKGARFV RFCDAFNIPL ITFVDVPGFL PGTAQEYGGI IRHGAKLLYA FAEATVPKVT VITRKAYGGA YDVMSSKHLC GDTNYAWPTA EIAVMGAKGA VEIIFKGHEN VEAAQAEYIE KFANPFPAAV RGFVDDIIQP SSTRARICCD LDVLASKKVQ RPWRKHANIP L (240-539 aa encoded by BC013768)
靶标信息
The protein encoded by this gene is a subunit of the propionyl-CoA carboxylase (PCC) enzyme, which is involved in the catabolism of propionyl-CoA. PCC is a mitochondrial enzyme that probably acts as a dodecamer of six alpha subunits and six beta subunits. This gene encodes the beta subunit of PCC. Defects in this gene are a cause of propionic acidemia type II (PA-2).
仅用于科研。不用于诊断过程。未经明确授权不得转售。
生物信息学
蛋白别名: PCCase subunit beta; Propanoyl-CoA:carbon dioxide ligase subunit beta; propionyl CoA carboxylase, beta polypeptide; propionyl Coenzyme A carboxylase, beta polypeptide; propionyl-CoA carboxylase beta chain (EC 6.4.1.3); Propionyl-CoA carboxylase beta chain, mitochondrial; propionyl-CoA carboxylase beta subunit; unnamed protein product
基因别名: 1300012P06Rik; AI314687; PCCB; R74805
UniProt ID: (Human) P05166, (Mouse) Q99MN9
Entrez Gene ID: (Human) 5096, (Mouse) 66904, (Rat) 24624